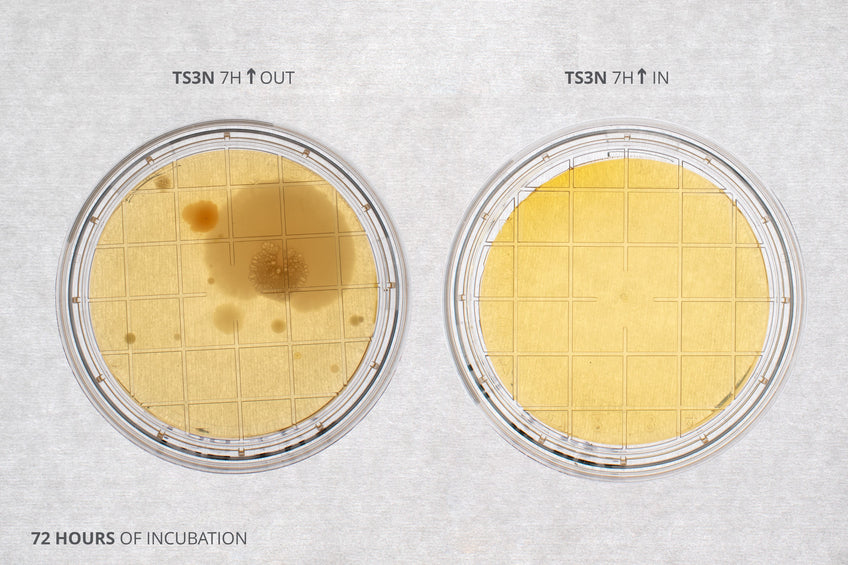
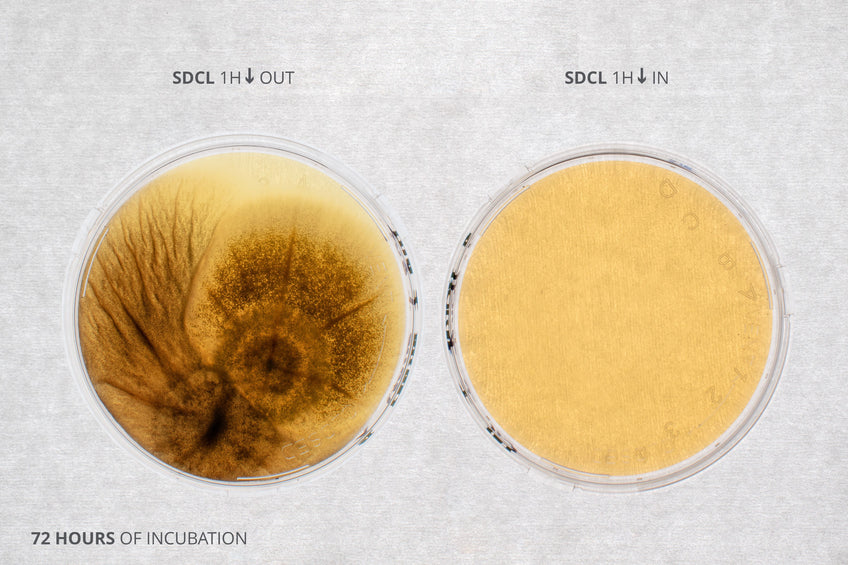
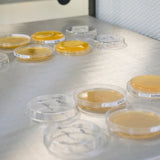

Contamination Control: How Ossila Laminar Flow Hoods Perform
When working with sensitive samples, you should be confident that a laminar flow hood can maintain a clean and contaminant-free environment. This is especially true during microbiological experiments and preparation, such as growing cell cultures or preparing media plates. You can test if the cleanliness of the air flow using settle plates and the surfaces using contact plates.
To check that our laminar flow hood is suitable for microbiological uses, we tested for air and surface contamination. In addition to testing within the hood, we also collected samples on a regular lab bench for comparison.
How to Test Levels of Contamination in a Laminar Flow Hood
We conducted these tests in our laminar flow hood in the horizontal configuration. Before starting air flow and surface testing, we cleaned the laminar flow hood following our recommended method.


To test the cleanliness of the air flow inside the Ossila laminar flow hood, we exposed Tryptic Soy Agar Contact (TS3N) plates and Sabouraud Dextrose Agar Contact (SDCL) plates to the internal environment. TS3N plates and SDCL plates will encourage growth of bacterial and fungal colonies, respectively. These plates were exposed for either 7 or 24 hours, before being sealed and incubated at 37°C for 72 hours.
To test how clean the surface is (after proper cleaning and exposure to the UV light), we placed TS3N and SDCL plates in direct contact with the tray. These plates were left for 1 hour, before being incubated at 37°C for 72 hours.
For both contact and air flow tests, we made comparison plates on a standard lab bench. This provides a control for how clean the laminar flow hood is compared to a normal laboratory environment.
Laminar Flow Hood

Air Flow Contamination
The results of our air flow tests are contained in the table below.
Agar Plate | No. of Colonies Outside Laminar Flow Hood (after 7 hours) | No. of Colonies Inside Laminar Flow Hood (after 7 hours) |
T3SN | 10 | 0 |
SDCL | 3 | 0 |
After 7 hours, the plate exposed to a normal laboratory environment were quite contaminated. There is evidence of both bacterial and fungal contamination. However, both plates exposed to the laminar flow hood environment were clean and uncontaminated. This proves that the laminar air flow, along with correct cleaning procedures, can sustain a sterile environment for up to 7 hours.

We also tested how long the laminar flow hood can prevent contamination, beyond the inital 7 hours. To do this, we left a plate exposed to the internal air flow in the laminar flow hood for 24 hours. After 24 hours in the laminar flow hood, no contamination was seen in either plate.


Surface Contamination
The results of our surface contamination tests are contained in the table below.
Agar Plate | No. of Colonies Outside Laminar Flow Hood (after 1 hour contact) | No. of Colonies Inside Laminar Flow Hood (after 1 hour contact) |
T3SN | 16 | 0 |
SDCL | 2 (majority coverage) | 0 |
After 1 hour in contact with a general lab bench, the plates had significant bacterial and fungal growth. However, the plates put in contact with the hood tray, which was cleaned following the recommended method, remained clear after incubation.

Maintaining a Contaminant-Free Environment
Our laminar flow hood creates an exceptionally clean workspace. This envrionment is maintained for extended periods, up to 24 hours in this instance.
By following correct cleaning procedure, the internal surfaces of our laminar flow hood are contaminat-free. Whereas, a general lab bench has significant levels of contamination.
These tests demonstrate the cleanliness of a laminar flow hood workspace, which is essential for working with sensitive or biological samples.
Laminar Flow Hood

Learn More

Colony counting is a key technique used in microbiology, offering critical insights into microbial populations in various scientific and industrial fields. This method allows researchers and professionals to estimate the number of microbes in a sample. It is the easiest and most common way to estimate the number of cells in a sample.
Read more...
Agar plates are important tools in microbiology used by researchers and scientists to study microorganisms. These plates consist of a petri dish with growth medium made of agar. They provide a controlled environment for microbial growth, including bacteria and fungi.
Read more...